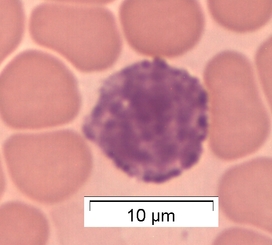

7.1 Erythrozyten Maus 7.1 Erythrozyten Maus
|
7.3 Eosinophile Granulozyten Maus
|
|
7.2 Basophile Granulozyten Maus Basophile Granulozyten machen maximal 1 % aller Leukozyten im Blutbild der Maus aus. | |
 7.1 Erythrozyten Maus 7.1 Erythrozyten Maus
|
7.3 Eosinophile Granulozyten Maus
|